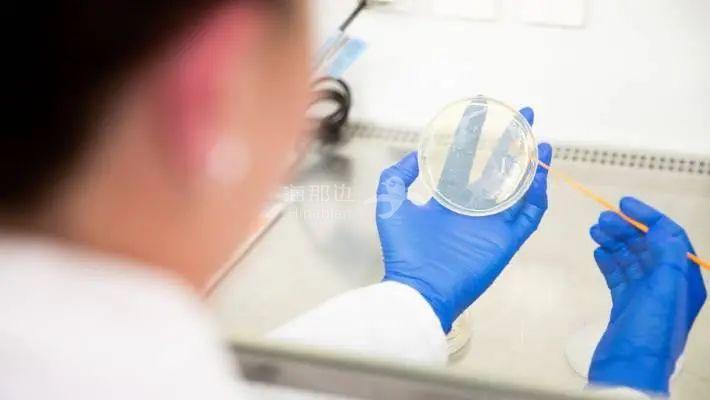
..

卫生部今天中午刚刚发布了一份新近的基因组检测结果的新闻稿,他们是这么说的:
(点击图片,加入移民交流群)
正在调查的两例奥克兰病例的基因组检测结果上午出炉,其中一例与奥克兰南区家庭感染群集有关。但另一个病例是一名男子,他是奥克兰Rydges酒店管理隔离设施的维修工人,与客人没有任何日常接触。而他的部分基因组检测结果表明,他的病例与社区传播集群无关。据悉,该病例于8月11日出现症状,8月16日星期日再检测为阳性,昨天被转移到Jet Park酒店隔离设施。
(点击图片,加入移民交流群)
根据基因组测序显示,7月28日至7月31日,一名与该维修工人序列相同的从美国海归人员在Rydges酒店隔离。结果,美国海归人员检测为阳性,并于7月31日被转移到Jet Park检疫设施。根据查看监控显示,在这期间,该维修工人和从美国海归之间没有明显的人际接触,两人之间没有互动。
(点击图片,加入移民交流群)
也就是说,虽然有同样病毒基因组测序,但美国海归早在7月31日被送到Jet Park酒店隔离。而位于奥克兰CBD的Rydges酒店维修工却在8月11日出现症状,这中间也许有无症状感染。
卫生部将做进一步的基因组检测和匹配工作,稍晚会有更详细的报告。
今天早上,总理Jacinda Ardern在接受AM Show采访时表示,奥克兰可能会在8月26日之前解除3级封锁。

(点击图片,加入移民交流群)

(点击图片,加入移民交流群)
Ardern说,在审查评估后,奥克兰有可能改变警报级别 ,“我们的目标是尽快解除锁定。”本周五,政府将视疫情作出评估,就继续封锁或终止封锁给出决定。“目前我不能给你任何暗示,因为我还没有坐下来与卫生总干事进行直接对话。”Ardern说,卫生总干事Ashley Bloomfield认为,两周的封锁应该是城市的“较大限度”。
(点击图片,加入移民交流群)

(点击图片,加入移民交流群)
昨天, Bloomfield提出了一个新的警报级别:在一级和二级之间——1.5级警报。这意味着经济可以保持开放,人们仍然可以参加大型活动。大家又会保持社交距离,更频繁的洗手,在一些场合下使用口罩。
今天上午,国家党党魁Judith Collins召开新闻发布会,表示2/3的边境人员未检测令人担忧。她认为,政府的边境检测很失败,并且,政府在这个问题上误导了公众。

(点击图片,加入移民交流群)
据她所知,一些边境工作人员一直不愿接受检测,有的工作人员并未接受检测,有的想接受检测却被拒绝了。她说“总理表示是沟通不畅的问题,我认为这是一次彻底的失败。”总理Jacinda Ardern今天承认此前边境工作人员的检测是不够的,但她似乎把矛头指向了公共卫生官员。
(点击图片,加入移民交流群)
当Newstalk ZB的主持人问到政府为什么没能发现检测不足时,她说我也想问卫生官员们这个问题。“目前,在这个问题上,不该由我提出关于测试制度的问题。”“我想要看到的是最终的结果。”“我对原因和借口不感兴趣,我关注的是,每一个前线边境工作人员都必须接受例行检测。”Ardern说,尽管新西兰边境工作工作人员检测不足,但她仍然对卫生和边境官员保持信心,她仍然对Bloomfield和负责管理隔离和检疫的空军准将Darryn Webb的工作有信心。
学校也传来好消息,在3级警报级别下,奥克兰校长们可以选择让12年级和13年级的学生提前返校了。
(点击图片,加入移民交流群)

(点击图片,加入移民交流群)
昨晚,教育部首席执行干事Iona Holsted向新西兰各学校表示,她今天将确认学生可以返校的时间。她说:“可能是8月19日星期三,或8月20日星期四。我们的目标是星期三。”
(点击图片,加入移民交流群)
•必须组织学校形成封闭社交圈,每个社交圈不超过20人,由一位老师指导。•在三级警报级别下,一位老师只能与一个学生社交圈相联,但一个学生社交圈的老师人数可以多于一位。•必须严格洗手并吹干,必须在教室入口处提供洗手液。
对于教育部的这一做法,奥克兰文法学校校长Tim O'Connor表示欢迎。他此前一直恳求当局给予校方灵活性,尤其是那些即将大考的高年级学生。不知道其它学校或是家长们是否放心让孩子返校。
对于第二波疫情最早发现病例的Mt Wellington的Americold冷冻仓库,他们收关3名工作人员的检测结果也出来了——都是阴性。
这也意味着,该冷库中的确诊病例数限制在了10例。

(点击图片,加入移民交流群)
Americold NZ的董事总经理Richard Winnall说,确诊病例中有7人是直接雇员,其余3人是合同工。
他对该报说,“我们相信,我们已经知晓了全部检测结果。”
Mt Wellington的冷库将一直关闭,直到表面检测工作完成,Winnall希望检测结果能在本周中公布。
此外,Winnall此前曾表示,Mt Wellington冷库出现的病例与墨尔本和新西兰之间的货运有关的说法是不可信的。
上周六,英文《先驱报》报道称,该公司已经调查了墨尔本和新西兰的冷库之间是否存在产品转移,结果是并没有。

(点击图片,加入移民交流群)
“我们可以完全排除病毒通过货物传播的可能性,”Winnall说,“这是不可能的,因为这两地之间(Mt Wellington和墨尔本)并不存在货运或供应链关联。”
第二轮疫情暴发以来,新西兰政府吸取以往教训,大大加强了检测力度。但随之而来的问题也日益显现。
(点击图片,加入移民交流群)
奥克兰的实验室几乎每天都在打破前一日之内的检测纪录,为了满足人们的检测需求,许多工作人员每天轮班12小时。Labtest的医务主任Gary McAuliffe说,他们正在处理比正常情况多10倍的检测量。实际上,自首要轮疫情暴发以来,实验室一直在为潜在的病例激增做准备。他说,实验室正在调动管理人员,临时招聘大学里的科研人员,并从其他地区的实验室获取帮助。
(点击图片,加入移民交流群)
Apex Union实验室主管David Munro说,当前的形势下,加班是常态,但在拥挤的实验室里,人们很难保持社交距离。“一些规程要求人们穿上全套个人防护装备,但就像一位代表对我说的那样,他们的汗出得像猪一样。”Labtest的McAuliffe表示,过了本周,人们恐怕很难继续保持这样的工作节奏。他说,如果检测需求持续保持在高位,卫生部应该考虑减少对其他地区、其他疾病的常规检测,这样实验室就有更多的能力应对奥克兰的新冠疫情。
(点击图片,加入移民交流群)
Apex的Munro警告说,长期的重复机械工作,可能导致工作倦怠,比如将样品放入机器中,或者一遍又一遍地取下盖子。Munro还说,老化的IT系统和机器很容易崩溃,如果检测数量不降,未来会造成很大的延迟。卫生部表示,没有考虑减少国内其他地区的常规检测,但正在考虑提高检测能力,并希望医生目前不要进行非紧急检测。
新西兰就这样不紧不慢的疫情,却遭到美国总统川普的“嫌弃”。
(点击图片,加入移民交流群)

(点击图片,加入移民交流群)
新西兰时间今天,川普在明尼苏达州发表讲话时说,新西兰再次出现了新冠病例“激增”,他不希望在美国看到这样的情况发生。
“你看看新西兰怎么样了?他们病例激增。太可怕了,我不想要这样。”真是搞笑了,新西兰昨天发现9例,而美国是42000例。截止目前,新西兰共报告了1280例,而美国为近560万例,超过17万人死亡。
【新西兰移民交流群】
请扫码 或 加微信号 NZ-hnb

(点击图片,加入移民交流群)
1